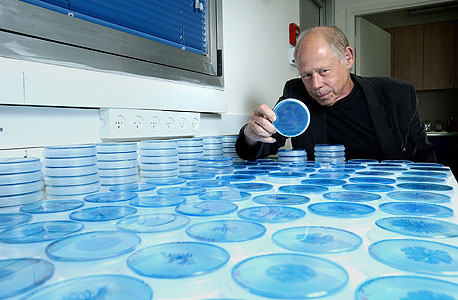
צילום: עמית שעל

02.02.12 אורן הוברמןכלכליסט |
מהנטייה להשמנה, דרך העדפת בני זוג ועד מצבי רוח, מחקרים פורצי דרך מעלים את האפשרות שאנחנו, בין היתר, אוסף החיידקים שמרכיבים אותנו
ברוס גרמן, פרופסור לכימיה מאוניברסיטת קליפורניה דיוויס, חוקר זה יותר מעשור את אחת החידות הגדולות ביותר הקשורות בחלב האם: ההרכב המשונה שלו. 21% מהסוכר בחלב אם עשוי מחומר שאף תינוק אנושי אינו מסוגל לעכל. "במשך שנים האמינו שזו טעות אבולוציונית", אומר גרמן בראיון ל"מוסף כלכליסט". "אבל זה לא ייתכן. חלב אם עוצב על ידי 200 מיליון שנות אבולוציה, תחת אילוצים אדירים. הוא חייב להיות חסכוני מאוד, כי הוא עולה לאם באנרגיות אדירות, וכל רכיב בו אמור להיות מדויק על שבריר האחוז, משום שכל מחסור עלול להזיק לתינוק. 21% מבוזבזים פשוט לא מסתדרים עם זה".
לגרמן היה רעיון. הוא חשב שהסוכר הבלתי מתעכל כלל לא מיועד לתינוק, אלא למישהו או משהו אחר, שחי בתוך התינוק. הוא וצוותו בודדו את הסוכר המסתורי ממאות דגימות חלב מאמהות מכל העולם, ומזגו אותו למאות צלחות פטרי שהכילו כ־400 זנים שונים של חיידקים שחיים בדרך כלל במערכת העיכול האנושית. אף זן לא שרד. החיידקים לא הצליחו לפרק את הסוכר וגוועו ברעב. רק ב־2009, שנתיים אחרי שהחלו את סדרת הבדיקות, אחד החיידקים הרים את ראשו. זה היה תת־זן של חיידק זניח בשם ביפידובקטריום לונגום, ובקיצור ביפידו. הוא היה בין האחרונים ברשימה להיבדק כיוון שבגופם של בני אדם בוגרים הוא כמעט ואינו קיים. במעבדה הוא מילא את הצלחת. גרמן מצא את החיידק שאוכל חלב אם.
כמה שאלות נותרו פתוחות: האם החיידק הזה אכן נמצא בגופם של תינוקות? ואם כן, למה דווקא אותו האמהות מזינות בחלב יקר הערך שלהן? למזלו של גרמן, הפעם מישהו כבר עשה עבורו את העבודה המלוכלכת. מלוכלכת תרתי משמע.
ד"ר ג'רמי קוניג, ביולוג מולקולרי מאוניברסיטת קורנל, הוא האיש היחיד בעולם שחקר באופן מדוקדק איך קהילת חיידקים צומחת מאפס לטריליון בגופם של תינוקות. במשך שנתיים הוא אסף 60 דגימות מחיתולים מלוכלכים של תינוק אחד, וניתח כל יצור מיקרוסקופי שמצא בהן. הוא תיעד עשרות סוגי חיידקים שבאו והלכו לאורך השנתיים הללו, אבל החיידק המשמעותי ביותר, קוניג דיווח, היה תת־זן של חיידק נדיר בשם ביפידו. "כשמצאתי את העבודה שלו הבנתי שקלענו", אומר גרמן.
עתה לגרמן נותר רק לגלות למה דווקא ביפידו. מה כה חשוב בחיידק הזה עד שהאם בעצמה מאכילה אותו. והתשובה נמצאה. הביפידו התגלה כשומר הראש הצמוד של התינוק. "זו עסקת החליפין הראשונה בחיינו, והיא נעשית לנו מעל הראש", אומר גרמן. "החיידק הזה מתרבה במערכת העיכול של התינוק ולזמן מה לא משאיר מקום כמעט לאף חיידק אחר. הוא היחיד שמסוגל לעכל את הסוכרים העודפים, וזה נותן לו יתרון על פני החיידקים האחרים, שנדחקים החוצה. ובאופן מעניין, זה קורה בדיוק בתקופה שבה לתינוק אין כמעט שום הגנה מפולשים. אין לו מערכת חיסון, נוגדנים או מיצי קיבה, ולמעשה הביפידו הוא שמגן עליו מבפנים, והוא ממשיך לעשות את זה כל עוד יש לו אספקה של חלב אם. חשוב על האסטרטגיה המבריקה של האבולוציה", הוא אומר, "אמהות מגייסות צורת חיים אחרת כדי שתעשה בייביסיטר לתינוקות שלהן".
100 טריליון שותפים
קצת אחרי שגילינו את האופטיקה, גילינו את החיידקים. הם תועדו בפעם הראשונה ב־1657 על ידי סוחר הבדים והמדען החובב אנטוני ואן לוונהוק, שהביט בהם מבעד למיקרוסקופ האור שפיתח. "גיליתי יצורים חיים קטנים מאוד במי גשם", כתב באיפוק באחד ממכתביו לחברה המלכותית של לונדון. אך התגלית זכתה לתגובות פושרות. תעיד על כך העובדה שרק כעבור 150 שנה נוספות היצורים הללו זכו לשם.
מאז ועד לעשורים האחרונים ממש, המדע ראה בחיידקים את הביטוי הפרימיטיבי ביותר לחיים. הם נתפסו כאוסף מכונות משתכפלות וחסרות תכלית, עיוורות למציאות סביבן, חסרות חושים ויכולת תקשורת בסיסית. "השאיפה היחידה של הבקטריה", כתב ב־1973 הביולוג הצרפתי זוכה פרס נובל פרנסואה יעקב, "היא לייצר שתי בקטריות". במשך דורות סברו שהשפעת החיידקים על חיינו זניחה, למעט כמה זנים שגורמים מחלות.
בעשורים האחרונים התבררה גודלה של הטעות. מגוון עצום של מחקרים חשף את היהירות האנושית במערומיה: לא רק שהחיידקים עיצבו את עולמנו יותר מכל יצור אחר, הם גם התגלו כצורת חיים מגוונת ומתוחכמת, ובעלת השפעה רבה וישירה על יצורים גדולים ומורכבים מהם בהרבה. כן, גם עלינו, גם כרגע.
חיידק הוא יצור חי שכולו תא אחד. כמונו, יש לו דנ"א שקובע את צורתו, תכונותיו ותוחלת חייו, שנמשכת בין דקות לשבועות. זעירותו בלתי נתפסת: על הנקודה בסוף המשפט הזה יכולים להצטופף 5 מיליון חיידקים. על גודלם הזעיר הם מפצים בכמות. מבחינה מספרית, הארץ שייכת להם. הם מהווים 50% מהמסה הביולוגית בעולם ויותר מ־99.9% ממגוון החיים בו. בכפית חול יש יותר מעשרת אלפים זני חיידקים שונים, יותר מכפליים מכל מיני היונקים הידועים לנו. וכל מקום שתנאיו מאפשרים שבריר חיים מתמלא מיד חיידקים. הם שבריר החיים הזה.
והם לא רק מציפים את העולם סביבנו. גם בתוך גופנו אנחנו בנחיתות מספרית מולם. "בני אדם הם ענן של בקטריות עם קליפה אנושית דקה מסביב", אומר ג'פרדי גורדון, מיקרוביולוג מוערך מאוניברסיטת וושינגטון, בראיון ל"מוסף כלכליסט". "על כל תא שלנו חיים בגופנו תשעה חיידקים. מניינם עוקף בקלילות את ה־100 טריליון, ומשקלם גדול מזה של המוח והכבד יחד".
התגלית הדרמטית של השנים האחרונות היא שענן הבקטריות הזה אינו דייר פסיבי בגוף. החיידקים משפיעים עלינו, כפי שהם משפיעים על פונדקאים אחרים שלהם בכל עולם החי, באלפי דרכים שונות התואמות לצורכיהם. החיידק ששומר עלינו כתינוקות הוא רק דוגמה אחת. "יש לנו תחושה שהתודעה שלנו, אי שם במוח, היא זו שמנווטת את הגוף שלנו בעולם", אומר ל"מוסף כלכליסט" ד"ר שרון מועלם, מומחה לביולוגיה אבולוציונית ומחבר רב־המכר "דווקא החלשים שורדים". "היום ברור לנו שזו אשליה. התודעה שלנו מורכבת מהרבה דברים, ובהם אזורים שונים במוח וגם מסרים כימיים שנשלחים אליו ממקומות שונים בגוף. ואם עד לאחרונה חשבנו שאפשר להסביר את הרוב באמצעות תורשה וסביבה, אם חשבנו שהכל זה גנטיקה, נוירולוגיה ופסיכולוגיה, עכשיו מתחילה לחלחל ההבנה שחייבים להכניס לתמהיל הזה גם את הטריליונים הרבים של החיידקים, הווירוסים והמיקרובים שחיים בתוכנו. לטוב ולרע, הם השותף הסודי לכמעט כל דבר שאנחנו עושים".
 | |||
| מועלם."חייים שפועלים לטובתך יעילים יותר מכל תרופה שבני אדם יפתחו" | צילום: צ'אד האנט | ||
השמנה היא וירוס
ב־2006 ג'פרי וצוותו באוניברסיטת וושינגטון חקרו את אחת התעלומות המוכרות (והמרגיזות) ביותר בקשר להשמנה: מדוע יש אנשים שאוכלים מעט ומשמינים, בעוד אחרים מעמיסים קלוריות ונשארים רזים. במשך שנים התשובה המקובלת היתה "גנים". אבל גורדון חשד שזה רק חלק מהסיפור.
במחקר שערך עם רות לי ופטר טורנבג הוא לקח שני עכברים שניזונו מאותו התפריט, ושאחד מהם השמין מאוד והאחר היה רזה מהרגיל. הוא בודד את החיידקים במערכות העיכול שלהם, והשתיל אותם בעכברי מעבדה רגילים וממוצעי משקל. התוצאות ניכרו בתוך שבועות: העכברים שקיבלו את החיידקים מהעכבר השמן העלו במשקל במהירות. אלו שקיבלו חיידקים מהרזה שמרו על משקלם, ואף רזו.
כשגורדון ערך בדיקה גנטית לאוסף החיידקים שנמצאו בגופם של העכברים השמנים, הוא מצא בהם גנים רבים שקשורים לפירוק פחמימות והמרצת פעילות כימית שמעודדת תיאבון וצבירת שומן בכבד ובשרירים. בחיידקים שהיו בגופם של העכברים הרזים הגנים הללו כמעט לא היו קיימים.
מחקר ההמשך שגורדון ערך עם רות לי גילה שההסבר עשוי להיות תקף גם לבני אדם: גורדון ולי מצאו את אותם חיידקים שזוהו בעכברים השמנים גם אצל בני אדם שסובלים שעודף משקל. בהתאמה, בקיבותיהם של אנשים רזים נמצאו חיידקים הדומים לאלה שאותרו אצל העכברים הרזים. "אנחנו מעריכים, וצריך עדיין להיות זהירים בזה, שייתכן שהשמנה היא בחלקה קשורה לחיידקים", אומר גורדון. "מתברר שכאשר חיידקים מסוימים רוצים שהפונדקאים שלהם יאכלו יותר - הם יודעים איך לעשות את זה".
ואז עלתה השאלה: אם חיידקים מסוגלים להשפיע על תיאבונם של עכברים, האם ייתכן שיש להם השפעה דומה גם על תחומים אחרים? במחקר שעורר הדים רבים, פרופ' חווייר בארבו מיוניברסיטי קולג' קורק באירלנד מצא שתזונה המלאה בחיידקים פרוביוטיים, אותם חיידקים שנמצאים גם ביוגורט, משפיעה ישירות על מוחם של עכברים ומשנה את אישיותם. איכשהו, החיידקים הופכים אותם לרגועים יותר ופחדנים פחות.
בארבו בדק את מוחם של העכברים שהוזנו בחיידקים הללו, ומצא שהיו בו יותר קולטנים של מוליך עצבי בשם GABA, שתפקידו להפחית את תזזיתיות היתר של הנוירונים במוח. תרופות נגד חרדה אצל בני אדם עובדות בדיוק באותה הדרך.
כשבארבו ניתק את העצב שמחבר בין מערכת העיכול של העכברים למוחם הקולטנים נעלמו, והעכברים חזרו להתנהגותם הקודמת. במחקר צרפתי שנערך בשנה שעברה, התגלה שטיפול בבני אדם עם מנות גדולות של פרוביוטיקה במשך 30 ימים רצופים גורם להשפעה דומה. הוא מקטין את החרדה של המטופלים ומפחית באופן זמני מצוקות פסיכולוגיות.
במחקר אחר התגלה שחיידקים לא רק משפיעים על מוחם של עכברים, אלא ממש לוקחים חלק בעיצובו. החוקר השבדי סוון פטרסון בודד קבוצה של עכברים בני יום במתקן זכוכית נטול חיידקים וגידל אותם שם בתנאים סטריליים, כדי לבדוק אם תהיה לכך השפעה על התפתחותם. התברר כי בלי החיידקים, מוחם של העכברים התעצב באופן חלקי: יותר ממאה גנים הפעילים בדרך כלל אצל עכברים רגילים לא זכו לביטוי. העכברים שגדלו בתנאים סטריליים איבדו את היכולת ללמוד דברים חדשים, סבלו מהיעדר אנרגיה והפגינו אפאתיות מוחלטת למתרחש סביבם.
משיכה היא חיידק
בעקבות הממצאים החלו חוקרים ברחבי העולם לבחון מחדש תעלומות לא מפוענחות בעולם החי, ותפקידם המפתיע של החיידקים צץ שוב ושוב. תעלומה אחת כזאת היא תגלית מוזרה מ־1989, שלפיה משיכה מינית בין זבובים מושפעת, משום מה, מהרגלי התזונה שלהם.
פרופ' דיאן דוֹד מאוניברסיטת ייל הראתה בשעתו במבחני מעבדה שזבובים שניזונים מאותו סוג אוכל נמשכים זה לזה יותר מלזבובים שניזונו ממזונות אחרים. היא גם גילתה שהם מורישים את הטעם המיני הזה לצאצאיהם. עשרות דורות של זבובים שמרו על טעם מיני דומה ונמשכו לצאצאי הזבובים שאכלו מזון דומה לזה שאכלו אבותיהם. מה שדוד לא הצליחה להסביר היה למה.
ב־2010 שלושה חוקרים ישראלים מאוניברסיטת תל אביב שחזרו את הניסוי, והפעם הם ידעו מה לחפש: הם הפרידו זבובים לקבוצות שונות, האכילו אותם בסוגי מזון שונים, ואחרי שנה איחדו בין הקבוצות. כמו בניסוי של דוד, הזכרים זיהו ללא קושי נקבות שאכלו מזון דומה לשלהם, והעדיפו להזדווג איתן. אלא שהפעם החוקרים הוסיפו עוד שלב לניסוי: הם האכילו את כל הזבובים באנטיביוטיקה, כדי לחסל את אוכלוסיות החיידקים בגופם. האנטיביוטיקה העלימה באחת את ההעדפות המיניות. הזבובים החלו להזדווג ללא הבחנה.
כדי לוודא שאכן מדובר בהשפעה של חיידקים, החוקרים, פרופ' יוג'ין רוזנברג, פרופ' דני סגל והדוקטורנט גיל שרון, חילצו מראש חיידקים מגופם של הזבובים, ולאחר ניסוי האנטיביוטיקה החזירו אותם לגופם. ההעדפות המיניות חזרו. "אלה לא הזבובים שבוחרים את הנקבות שהכי מתאימות להם, אלה החיידקים שמושכים את הזבובים לחיידקים כמותם", אומר יוג'ין רוזנברג ל"מוסף כלכליסט". "אנחנו מעריכים שזו אסטרטגיה שנועדה לעזור לחיידק לחזק את האחיזה שלו באוכלוסיית הזבובים", מסביר גיל שרון. "אם שני פרטים שאוכלים את אותו הדבר מזדווגים, יש סיכוי גבוה יותר שהחיידק שמתמחה בפירוק המזון הזה יהיה גם בדור הבא שלהם".
 | |||
| רוזנברג. "חיידקים מטים את ההעדפה המינית של הפונדקאי שלהם, כדי לעבור לדור הבא" | צילום: אוראל כהן | ||
השיגעון נבע מהרפס
ד"ר מארק היימן, רופא משפחה שפרסם ארבעה רבי־מכר בנושא תזונה ורפואה מונעת, מספר באחד מספריו על מטופלת שלו שסבלה מהפרעה טורדנית־כפייתית של ניקיון (OCD). היא צחצחה את הבית שעות מדי יום, וכל פריט שהוזז ממקומו הוציא אותה מדעתה. ריטלין, נוגדי דיכאון ואפילו תרופה נגד אפילפסיה שלעתים ניתנת לחולי נפש - דבר לא עזר. היימן מספר שההפרעה הרסה לה את החיים.
מה שמוזר הוא הדבר שריפא אותה: כאבי בטן. באחת הפעמים שביקרה את היימן היא התלוננה על כאבי בטן, ובהיותו רופא משפחה הוא רשם לה אנטיביוטיקה. כמה ימים אחר כך היא התקשרה אליו, וסיפרה לו שה־OCD עבר לה לגמרי. שנים של טיפולים פסיכיאטריים לא הצליחו לעשות את מה שעשו כמה כדורי אנטיביוטיקה.
"המשכנו לחקור את המקרה שלה", מספר היימן, "מתברר שלכל הצרות שלה היה אחראי חיידק שהתיישב לה במערכת העיכול וייצר כמויות גדולות של אמוניה, רעלן עצבי שמגיע עם זרם הדם למוח ומגרה את תאיו. זה היה מקור השיגעון שלה, וחיסול החיידק חיסל את ההשפעה".
ד"ר מועלם מספר שבשנים האחרונות, מאז עלתה המודעות להשפעות ההתנהגותיות של חיידקים, וירוסים וטפילים אחרים על בני אדם, מתגלים עוד ועוד מקרים כאלה. "לפני כמה שנים קולגה הזמין אותי בדחיפות לראות ילד בן ארבע שמטופל אצלו", הוא מספר, "ההורים שלו היו בהיסטריה. הם סיפרו שהגננת התלוננה שהוא מטריד מינית את חבריו בגן, נוגע בהם ובעצמו, דוחף דברים לפה ולעתים מתנהג כמו מישהו אחר, כמו אחוז דיבוק". מועלם פגש בילד לראשונה בעיצומו של מופע אימים. "ראיתי פעוט עושה 'האמפינג' לספה בחדר הקבלה של הרופא, כמו שכלבים עושים. זה היה מחריד. מסוג הדברים שאתה לא שוכח", הוא מספר.
הוא החל לתחקר את ההורים. "תחילה חשדתי שמדובר בהתעללות מינית, אבל זה לא הסתדר עם שאר הפרטים", הוא נזכר. הוא הציע לשלוח את הילד לבדיקות דם, ואלה גילו שהילד חולה בהרפס.
וירוס ההרפס עובר לרוב דרך סדקים זעירים בעור, ואפשר להידבק בו גם במגע ישיר עם נשאיו וגם במגע עקיף. לרוב הוא גורם לנזקים קטנים בלבד - פצעים על השפתיים ובאיברי המין, ובמקרים נדירים מחלת הנשיקה ואדמת. אין תיעוד להרפס שגרם לשינוי התנהגות קיצוני באדם בוגר.
מועלם נתן לילד טיפול תרופתי נקודתי נגד הרפס, וביקש מהוריו להביאו לביקורת מדי יום. ההרפס חלף כעבור שבוע, ואיתו ההתנהגות המוזרה, על כל מאפייניה. "הניחוש שלי הוא שהנגיף הוא שהשפיע על התנהגות הילד, ושאופן ההשפעה הספציפי הזה קשור לעובדה שהווירוס הזה עובר לעתים קרובות במגע מיני. זה לגמרי הניחוש שלי, אבל לדעתי זה מה שהוא ניסה לעודד את הילד לעשות".
מאז תועדו בעולם עוד כמה מקרים כאלה, שכולם נפתרו באמצעות חיסול הנגיף. "אצל מבוגרים לא נתקלנו מעולם בתופעה הספציפית הזאת", אומר מועלם. "אנחנו מעריכים שזה מנגנון שההרפס פיתח במקור כדי לעודד מבוגרים להדביק אחרים, אבל מערכת החיסון שלנו למדה ליירט אותו. כנראה אצל ילדים, שמערכת החיסון שלהם פחות מפותחת, הוא קיבל הזדמנות שנייה".
מועלם אומר שהשפעות כאלה, ברמות שונות של תחכום, משמשות סוגים רבים של טפילים מזיקים המנסים להפיץ את עצמם באמצעות הפונדקאי שלהם. "אפילו בצינון", אומר מועלם, "החיידק עושה שני דברים חכמים: הוא דואג לא להחליש אותך יותר מדי, כדי שתוכל להמשיך להסתובב בין בני אדם, והוא זה שמפעיל, מבפנים, את רפלקס העיטוש, וכך גורם לך להפיץ אותו. יש חיידק בשם סטרפטוקוקוס שמייצר דלקת גרון, וגורם לעתים לילדים ולמבוגרים לגעת בדברים באופן כפייתי. זו גם הדרך שבה הוא עובר מנשא לנשא. כלבת גורמת לכלבים להזיל ריר ולנשוך אחרים משום שהיא עוברת רק במגע של רוק ודם. מלריה, לעומת זאת, ממוטטת אנשים מחולשה. היא עוברת דרך יתושים, ומעדיפה שהאנשים לא יזוזו ויאפשרו ליתושים אחרים לעקוץ אותם ולהידבק".
 | |||
| תקריב של תרבית חיידקים מהמעבדה של אשל בן יעקב. מכונות מידע | |||
לתאונת דרכים גרם זיהום
אחד הטפילים המתוחכמים בעולם קרוי טוקסופלזמה־גונדי. גם אם השם לא מצלצל לכם מוכר, יש סיכוי שאתם נושאים אותו. הוא מקנן באחוזים ניכרים מאוכלוסיית העולם, בני אדם ויונקים אחרים גם יחד, אבל אוהב במיוחד חתולים. הוא גם מוכן לעשות הרבה בשביל להגיע אליהם. כשהוא מדביק עכברים זכרים (על נקבות הוא כמעט אינו משפיע), הוא גורם להם - בניגוד מוחלט לנטייתם הטבעית - להימשך לשתן של חתולים, ובכך להיטרף במהרה על ידי הפונדקאי המועדף עליו.
עד לאחרונה הדעה הרווחת היתה שטוקסופלזמה לא גורם למחלות אצל בני אדם, למעט נשים שנדבקות בו במהלך ההיריון - אז הוא מסוכן ממש, לאם ולתינוק גם יחד. זו הסיבה המרכזית לכך שנשים הרות מוזהרות לשמור מרחק מארגז החול של החתול ומסושי ובשר נא, שכן נבגיו עשויים להימצא בשני אלה.
אלא שבעשור האחרון מצטברות עדויות לקשר מסתורי בין הטפיל הזה לבין סיבת מוות שעד כה לא נקשרה בשום דרך לחיידקים - תאונות דרכים. הסימן הראשון היה כשכמה בתי חולים בארצות הברית החלו, בנפרד זה מזה ובנוהל מקומי, לחפש טוקסופלזמה בדמם של נהגים שהיו מעורבים בתאונות קשות, כחלק מסדרת הבדיקות הנעשות בטרם איבריהם מועברים להשתלה. הסיבה לחיפוש דווקא את הטפיל הזה היתה שבאופן מוזר, הוא כמעט תמיד היה שם.
ב־2002 החליט הביולוג הצ'כי-פולני פרופ' ירוסלב פלגר לחקור את צירוף המקרים המוזר הזה. הוא חיפש טוקסופלזמה בגופם של 146 גברים ונשים שהגיעו לביקורת רפואית אחרי תאונת דרכים, והשווה את התוצאות ל־446 אנשים שנבחרו באופן אקראי. שכיחות הנגיף בקרב המעורבים בתאונות היתה גבוהה פי 2.5 מבקבוצת הביקורת.
ב־2003 הוא בדק 3,890 איש, כולם נהגים בצבא הצ'כי. כעבור חמש שנים הצליב את רשימת נשאי הטוקסופלזמה בקרבם עם נתוני תאונות הדרכים של המשטרה הצבאית. התוצאה: הסיכוי של נהג בצבא צ'כיה להיות מעורב בתאונה הוא 2.7% אם הוא לא נגוע בטוקסופלזמה, ו־16.7% אם הוא כן נגוע. פי שישה. "יכול להיות שזה קשור לכך שהטפיל מאט את זמני התגובה בשרירים", הסביר פלגר באחד הראיונות שהעניק. "או אולי בהשפעה הורמונלית שגורמת ללקיחת סיכונים מוגברת. האמת היא שאין לנו מושג".
עוד בטרם הסערה הזאת שככה, הטפיל הראה כישרון נוסף: הוא גורם לנשים שנדבקו בו ללדת זכרים בהסתברות גבוהה משמעותית מנקבות. זה התגלה לראשונה במחקר על עכברות שנדבקו בנגיף, והמשיך בבדיקה סטטיסטית מקיפה שערך פלגר בנתונים של שלושה בתי חולים גדולים בפראג. הבדיקה העלתה שלנשים שנדבקו בטוקסופלזמה נולדו 72% בנים ו־28% בנות - לעומת החלוקה הנפוצה בעולם, של 51% בנים ו־49% בנות.
"השפעה על מין הצאצאים היא מסוג הדברים שטפילים וחיידקים מתמחים בו, לפחות בעולם החרקים", אומרת ד"ר עינת צחורי פיין, אנטומולוגית (חוקרת חרקים) זוכת פרס וולף ממכון וולקני. "אחת הדוגמאות הטובות ביותר לזה היא חיידק בשם וולבכיה, שנמצא במחצית מסוגי החרקים בעולם. אחת הסיבות להצלחה שלו היא שהוא מצמצם כל הזמן את האוכלוסייה שאינה נגועה בו. אצל חלק מהחרקים, למשל, הוא עובר דרך האמא לצאצאים, אבל האבא לא מעביר אותו לשום מקום. במקרים האלה הוא פשוט דואג שיהיו פחות זכרים, באמצעות שינוי האיזון ההורמונלי בזמן הטלת הביצים. בגלל הוולבכיה אתה נתקל בטבע בהרבה מאוד חרקים שיחס המינים שלהם מופרע. יש פרפר אפריקאי שבתוך כמה שנים השתנה איזון הזכרים־נקבות שלו ל־99% נקבות. ועוד דבר יוצא דופן עם החיידק הזה, זה שהוא משנה את האסטרטגיה בהתאם לחרק. אצל חרקים שבהם הזכרים מעבירים אותו לדור הבא, הוא משאיר את הזכרים בחיים".
| |||
| בן יעקב. "אפשר להשוות את מנגנון התקשורת של החיידקים להצבעה דמוקרטית" | צילום: עמית שעל | ||
על מה חיידקים מדברים
איך יצורים כה זעירים ופשוטים משפיעים בכזו עוצמה על מארחיהם? בוני בסלר, פרופ' למיקרוביולוגיה מאוניברסיטת סטנפורד, נשיאת האגודה האמריקאית למיקרוביולוגיה וזוכת פרס מקארתור היוקרתי, מצאה לפחות חלק מהתשובה: הם מתקשרים ביניהם.
בסדרת מחקרים פורצי דרך היא וצוותה הצליחו להוכיח לראשונה שמושבות בנות מיליארדי חיידקים מנהלות תקשורת פנימית עניפה ומורכבת, עם שפה ייחודית, סימנים מוסכמים וחלוקת תפקידים ברורה. התקשורת החיידקית נעשית באמצעות מולקולות זעירות שכל חיידק משחרר לסביבתו בפולסים קבועים. "זו שפה כימית עשירה עם לקסיקון נפרד שייחודי לכל זן חיידקים", היא מסבירה בראיון ל"מוסף כלכליסט". "באמצעות השפה הזאת הם מסוגלים לעשות 'ספירת ראשים' כדי לדעת עד כמה הקהילה שלהם גדולה, הם יכולים להזהיר חיידקים אחרים בקהילה שלהם מפני איומים מבחוץ, והם יכולים לשדר גם מידע מורכב יותר - כמו כמה גדול האיום הזה ואיך כדאי להגיב אליו.
"כשהבנו איך השפה הזאת עובדת, פתאום מגוון גדול של תופעות משונות בעולם החי קיבל הסבר פשוט", אומרת בסלר. "דוגמה מצוינת היא דיונון בשם בובטייל הוואי שיכול להאיר מהבטן. העניין המשונה הוא שהוא עושה את זה רק בערב, ושהאור הזה נדלק בבת אחת.
"מי שמייצר את האור עבורו הוא חיידק ימי בשם ויבריו פישצ'רי. מיליונים ממנו. העניין הוא שהחיידק הזה לא מאיר בדרך כלל. הוא עושה את זה רק כשכמות החיידקים במושבה שלו מגיעה לרמה מסוימת. כשזה קורה, כולם מדליקים את האור בו־זמנית. אבל איך כל חיידק בנפרד יודע מתי להידלק? מצאנו שיש להם סימן מוסכם. לכל חיידק וחיידק יש קולטן מיוחד לריכוז של מולקולת תקשורת בסביבה שלו, וכשהריכוז מגיע לנקודה מסוימת, הוא נכנס לפעולה".
למה החיידק הזה בכלל מאיר?
"החיידקים מהזן הזה חיים בתוך שני כיסים שקופים בחלק התחתון של גוף הדיונון. הדיונון הזה צד בלילות, ובמים רדודים יחסית, כך שאור הירח והכוכבים חודר אליהם. יוצא שבכל מקום שהדיונון מגיע אליו הוא מטיל צל, וגם הטורפים שלו וגם הניצודים שלו יכולים להבחין בו. אז מה שהדיונון פיתח זה מין מנגנון תאורה מתוחכם שמבוסס על החיידקים. על הגב שלו יש גלאים שבעזרתם הוא חש כמה אור פוגע בו מלמעלה. אז, באמצעות החיידקים ותריסים טבעיים שיש לו בגוף, הוא יכול להקרין את אותה כמות אור אל תוך המים ולהעלים את הצל. במהלך היום החיידקים האלה לא מאירים. הוא נפטר מרובם בבוקר, ואלו שנשארים מתרבים בדיוק עד הערב, בדיוק בזמן שהוא צריך לחזור לצוד".
שפת החיידקים החדשה היתה גילוי מפתיע, אך לא השיבה באופן מספק לשאלה הגדולה: איך הם מבצעים פעולות כה מורכבות. קדיחת שיניים אנושיות, למשל, היא משימה מורכבת שדורשת שיתוף פעולה מושלם של מאות זנים שונים של חיידקים. כמה מהם מנטרלים את הרוק, כמה מפרישים חומצות לחירור האמייל, ואחרים מפרקים את הסוכר שנדבק לשיניים כדי שיהיה לכולם מה לאכול. זה צבא שלם. "היה לנו ברור שכדי לתפעל מערך כזה חייב להיות עוד סוג של תקשורת", אומרת בסלר.
והתקשורת הזאת אכן נמצאה. "הופתענו לגלות שיש לחיידקים עוד שפה, עם לקסיקון שונה לגמרי מהראשונה", היא אומרת. בסלר וחוקרים אחרים מצאו שרוב החיידקים מצוידים באנזים שמייצר סוג נוסף של מולקולות תקשורת, וקולטן נפרד שקורא רק אותן. את ה"שפה השנייה" כל החיידקים יכולים להבין. "זו מין שפת אספרנטו חיידקית, שמאפשרת להם לקיים דיאלוג חוצה־זנים", מסבירה בסלר.
התקשורת הגלובלית, ושיתוף הפעולה שהיא מאפשרת, נותנת לחיידקים יכולות אדירות. "תחשוב על 5,000 בעלי מקצוע שונים שעובדים יחד, בעוצמה משותפת של 100 מיליארד פריטים", היא אומרת. "הם יכולים לעשות הכל".
 | |||
| כך (בערך) נראה חיידק | צילום: שאטרסטוק | ||
לרגל אחרי החיידק
99% מהחיידקים בגופנו טובים לנו. אבל יש גם מיעוט זעיר שלא. עד ממש לאחרונה המיעוט הזה היה הבעיה הכי בוערת של האנושות. במאה ה־14 חיידק יחיד בשם ירסיניה פסטיס חיסל יותר משליש מאוכלוסיית אירופה, במה שכונה "מגיפת הדבר השחור". אחרי כמה מאות שנים החליף אותו חיידק הכולרה, שהרג מיליונים בהודו, סין, רוסיה ואמריקה. בעשורים האחרונים זו השחפת, שחיידקיה קוטלים 3 מיליון איש בשנה, רובם ככולם בעולם השלישי. ההיסטוריה רצופה מגיפות כאלה. הביולוג־גיאוגרף ג'ארד דיימונד מנה כמה מהן בספרו זוכה הפוליצר "רובים, חיידקים ופלדה", וקבע שהחיידקים, על האסונות הדמוגרפיים שהביאו איתם, הם אחד הגורמים המרכזיים שעיצבו את התרבות האנושית.
ב־1928 הרופא הסקוטי אלכסנדר פלמינג גילה את הפניצילין ושינה באחת את מאזן הכוחות בינינו לבינם. האנטיביוטיקה נולדה, והבטיחה להוריד שאולה את החיידקים הרעים. למשך כמה עשרות שנים אנטיביוטיקה היתה הנשק האולטימטיבי נגד חיידקים באשר הם. היא הרגה את כולם, הרעים והטובים. מחלות שהרגו מיליונים, משפעת עד שחפת, רופאו בעזרת כדורים. זה היה נס, שהביא לפלמינג תהילה עולמית ופרס נובל. אבל הנס לא החזיק זמן רב. באמצע המאה ה־20 התברר שכמה חיידקים מזיקים מצאו דרך לשרוד את האנטיביוטיקה, וזכו ביתרון תחרותי, התרבו וכבשו את השטח. ומאז מתחולל מירוץ חימוש שבו בני האדם משקיעים מיליארדים בפיתוח אנטיביוטיקות חדשות, והחיידקים מתגברים עליהן במהירות מתסכלת.
נכון להיום, אנחנו מפסידים במלחמה הזאת. המרכז האמריקאי לבקרת מחלות ומניעתן הגדיר לאחרונה את העמידות העולה לאנטיביוטיקה "אחת הבעיות הדחופות בעולם כיום", והעלה חשש לכך שהמגיפה הקטלנית הבאה קרובה משנדמה. בארגון הבריאות העולמי מהמרים על אחד מזני השחפת החדשים שנמצאו לאחרונה, העמידים לחלוטין לכל סוגי האנטיביוטיקה בשוק. "השחפת מעולם לא נעלמה", אמרה לרויטרס סוזנה ג'קאב, בכירה בארגון הבריאות העולמי. "היא מתפתחת עכשיו בצורה נקמנית במיוחד".
אז מה עושים? "אנחנו מבינים עכשיו שאי אפשר להמשיך להילחם בקבוצות גרילה באמצעות הפצצה מהאוויר", אומר מועלם. "בטווח הקצר זה נראה כאילו הבעיה נפתרה, אבל בטווח הארוך המעטים ששורדים נוטים להיות הקיצוניים ביותר, וגם המופרעים ביותר. אנחנו חייבים נשק אחר לגמרי".
ומשם גם מגיע אחד מכיווני המחקר המבטיחים ביותר בתחום: מלחמה בחיידקים באמצעות שימוש בטכנולוגיה שלהם. "אם אנחנו יודעים שיכולתם לתכנן מתקפה אלימה קשורה ישירות ליכולתם לשוחח זה עם זה", אומרת בוני בסלר, "מה יקרה אם נשבש להם את התקשורת הזאת?".
את המחקר הראשון בנושא ערכה בסלר עם חיידקי כולרה. היא פיתחה מולקולה שננעלת בקולטני התקשורת של החיידקים, ומנטרלת את יכולתם לקבל מסרים מחיידקים אחרים. לאחר מכן היא הדביקה עכברי מעבדה בכולרה ונתנה להם לאכול תמיסה עם המולקולות שפיתחה. לרוב, עכברים אינם שורדים יותר מכמה ימים אחרי שנדבקו בכולרה. אצל עכברי המעבדה שלה המחלה מעולם לא התפרצה. "דרוש עוד הרבה מחקר, אבל אני מאמינה ששם טמון הדור הבא של האנטיביוטיקה", אומרת בסלר. "אנחנו מנסים עכשיו ללמוד את השפה שלהם. אם נצליח, נוכל לרגל אחרי המסרים שהם מעבירים ביניהם וגם לשתול מסרים משלנו".
בשורה נוספת מגיעה מקבוצת מחקר גדולה הכוללת מאות מדענים מרחבי העולם ומכונה "פרויקט המיקרוביום האנושי". מטרתה לפצח את הקוד הגנטי של חיידקים שחיים בגוף האדם, בדיוק כפי שפוצח הגנום האנושי. הקבוצה קיבלה ב־2007 150 מיליון דולר מהממשל האמריקאי, כדי שתוכל לבצע ניתוח גנטי מלא של יותר מ־600 חיידקים. "זה פרויקט מעניין מאוד", אומר שרון מועלם. "פיצוח הגנום האנושי היה אכזבה במובנים רבים. חשבנו שנחשוף את הקוד שמרכיב אותנו, אבל מצאנו המון חורים גדולים ומעט מידע מסביב. התקווה הגדולה היא שהגנום של החיידקים יוכל להשלים חלק מהחורים האלה".
לאכול חיידקים של אחרים
אבל המדע, ובטח הרפואה, מתקדמים לאט. גם החוקרים האופטימיים ביותר מעריכים שיידרשו לנו לפחות עוד שני עשורים בטרם נוכל להשפיע על עולמם של החיידקים ללא השימוש המזיק באנטיביוטיקה. ומה עד אז? אחת התשובות המפתיעות לשאלה הזאת הגיעה בשנים האחרונות מבית חולים באוסטרליה. לא היתה מעורבת בה טכנולוגיה מהפכנית, אפילו להפך. למעשה היא הועתקה, בשינויים קלים, מתרבות עתיקה שעד היום נשמרת מכל טכנולוגיה שהיא.
זה החל כניסיון הצלה אחרון לבחורה אוסטרלית שמערכת העיכול שלה הפסיקה לתפקד, ושום טיפול לא עזר: היא איבדה משקל, ובריאותה הידרדרה עד סכנת חיים. ברגע האחרון גסטרולוג מקומי בשם תומס בורודי פגש אותה, והעלה את הסברה שהבעיה אינה באיברים הפנימיים ולא בדלקת כלשהי, אלא שאוכלוסיית החיידקים שיושבת דרך קבע בקיבה שלה נכחדה, והוחלפה בחיידקים אחרים ועוינים. הפתרון שהציע היה למצוא דרך להחזיר לקיבתה את החיידקים ה"טובים" שהיו בה בעבר.
המדע המודרני יודע להרוג חיידקים, אבל החלפת אוכלוסיות חיידקים בתוך גוף האדם היא משהו שעוד לא נוסה. לא על ידי רופאים לפחות. הסיפור היחיד על השתלת חיידקים התגלגל במשך עשרות שנים כשמועה, עד שהועלה לראשונה על הכתב ב־2001, על ידי הביולוג האמריקאי ראלף א' לוין. לוין, שבין היתר חקר שיטות ריפוי בתרבויות קדומות, סיפר על תרופה בדואית מסורתית לדיזנטריה: אכילת צואת גמלים. הוא מצא תיעוד לשימוש בטיפול המאוד מיוחד הזה במלחמת העולם השנייה, כשחיילים גרמנים לקו בהרעלת קיבה באפריקה, וכמה מהם, בייאושם, התגברו על הגועל והעזו לנסות את תרופת האליל הבדואית. והם החלימו בתוך שעות. החיידקים שחיים בקיבות הגמלים הם מחסלי דיזנטריה מיומנים, ופשוט עברו בשלמותם למערכת העיכול של החיילים.
בורודי, שהיה מעריץ של לוין, קיבל אישור מיוחד מבית החולים לנסות על החולה האוסטרלית טיפול בהשראת הסיפור. הוא ביקש מבעלה של האשה הגוססת דגימת צואה, בודד ממנה את החיידקים שמצא בה, והכניס אותם לגלולות לבליעה עטופות מעטה פלסטיק. הוא קיווה שחיידקי הקיבה של בעלה יגיעו לקיבתה, ויצליחו לכבוש אותה מידי הפולשים. "זה היה קוריוז בהתחלה", אומר ד"ר אורי גופנא, מומחה למיקרוביולוגיה מאוניברסיטת תל אביב שעוקב באדיקות אחר התפתחות הטיפול מימיו הראשונים, "הדעה המקובלת היתה שהאוסטרלים פשוט משוגעים".
ואז הגיעו התוצאות. החולה האוסטרלית החלימה בתוך שבועיים. מאז הטיפול בוצע בעשרות מקרים דומים באוסטרליה, וב־2008 אומץ על ידי אוניברסיטת מינסוטה והחלו לבצע אותו גם בארצות הברית. עד כה מאות חולים בעולם עברו את הטיפול, בשיעורי הצלחה חריגים של 90%–95%. "מתברר שחיידקים טובים אפקטיביים יותר מכל תרופה", אומר שרון מועלם.
אז אולי כל מה שצריך לעשות זה ללמוד מה החיידקים הטובים עושים נכון.
"אני חושב שבאופן כללי יש לנו הרבה מה ללמוד מהם. ככל שאנחנו, עם המוח הגדול שלנו, הפכנו למסובכים יותר, הם הפכו ליעילים ומדויקים יותר במיניפולציות שהם מפעילים עלינו. עצם הניסיון להבין אותם הוא התקדמות אדירה בשבילנו. זה לא טריוויאלי, להבין שמישהו מפעיל אותך".
